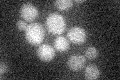
YLR357W
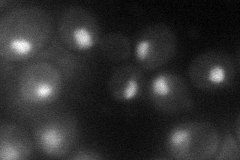
YLR357W

View description
Component of the RSC chromatin remodeling complex; required for expression of mid-late sporulation-specific genes; involved in telomere maintenance
Localization:
Intensity:
Fold change:
Significance:
-
C’ GFP library in SD
below threshold15.04 -
N' NOP1pr-GFP in SD
nucleus,nucleolus37.451 -
N' TEF2pr-mCherry in SD

missing0 -
N' NATIVEpr-GFP in SD

below threshold23.4336 -
N' TEF2pr-VC and Cyto-VN in SD

#N/A0 -
C’ GFP library in SD+DTT

cytosol16.541.09No -
C’ GFP library in SD+H2O2

cytosol13.450.89No -
C’ GFP library in Starvation Media

cytosol17.211.14No -
C’ GFP library on the background of Pup2-DaMP

below threshold -
C’ GFP library on the background of CCT mutant

below threshold17.93241.19172No
